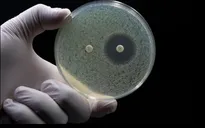

Theo WHO, cứ 6 ca nhiễm khuẩn được xác nhận thì có 1 ca kháng lại điều trị bằng kháng sinh. Tình trạng này khiến ngay cả những vết thương nhỏ hay bệnh nhiễm trùng thông thường cũng có thể trở nên nghiêm trọng.
Trong 5 năm qua, mức độ kháng kháng sinh đã tăng ở hơn 40% số loại thuốc được theo dõi, với tốc độ từ 5 - 15% mỗi năm.

(Ảnh minh họa: Intrust)
WHO ước tính vi khuẩn kháng thuốc trực tiếp gây ra hơn 1 triệu ca tử vong và góp phần vào gần 5 triệu ca tử vong mỗi năm. Tỷ lệ kháng thuốc cao nhất được ghi nhận ở Đông Nam Á và Đông Địa Trung Hải, nơi cứ 3 ca nhiễm bệnh thì có 1 ca kháng thuốc.
Trước tình trạng ngày càng cấp bách, WHO kêu gọi các quốc gia hành động khẩn cấp để ngăn chặn "đại dịch thầm lặng" này.

Bình luận (0)